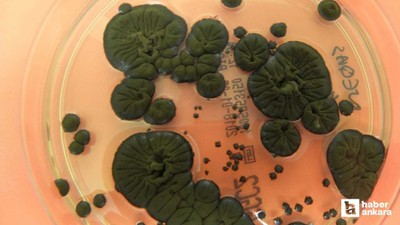
Çernobil’de radyasyon yiyen mantar keşfedildi

Yaz aylarında sıcaktan kurtaran vantilatörler büyük bir ilgi görüyor. En çok kullanılan soğutma sistemlerinden biri olan vantilatör hakkında bazı detaylara dikkat etmek gerekiyor. Vantilatör alacaklar ise konu hakkında araştırma yapıyor.
Vantilatör alırken nelere dikkat edilmeli, kaç watt olmalı?
Sıcak havalarda vantilatör büyük bir kurtarıcı olduğu için yaz aylarının vazgeçilmezi oluyor. Vantilatör alacakların ise bazı noktalara dikkat etmesi gerekiyor.